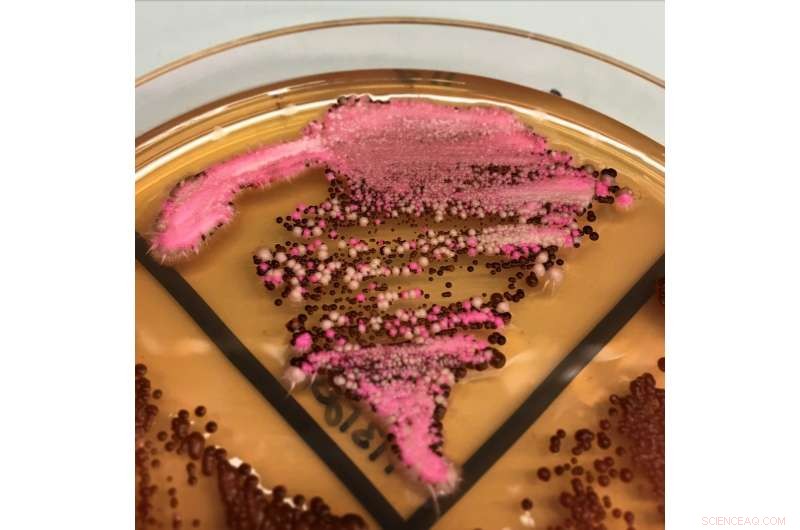
Eliminating Drug Resistance in Fungi Using Gene Drives

Multicolored diploid Candida albicans fungi growing on an agar plate with red-colored colonies indicating that two copies of a marker gene have been effectively deleted by the gene drive. Credit: Wyss Institute at Harvard University
Candida albicans is a notorious human fungal pathogen that causes thrush and serious systemic infections. Opportunistic C. albicans fungi, which often live inconspicuously in the normal flora of human skin and gut, can switch from their harmless stealth mode to become aggressive pathogens, especially in people whose immune systems are already compromised by pre-existing diseases or harsh drug therapies. They can also form biofilms on medical devices, such as catheters and stents in the human body, leading to infections and sometimes death. The threat posed by both free and biofilm-bound forms of the pathogen is constantly growing, as virulent C. albicans strains are becoming increasingly resistant to the few drugs that are available to treat them.
Microbiologists are facing tremendous difficulties in their quest to fight C. albicans' drug resistance and biofilm formation. Each C. albicans microbe is a "diploid" organism, as it usually contains two copies of its entire genome and of all the genes encoded within. However, to understand the role that a specific gene plays, researchers need to be able to delete both copies at the same time, allowing them to observe the effects of the gene's total absence, which has been a difficult challenge in C. albicans. In addition, genes often play very similar and sometimes redundant roles in many processes, including drug resistance and biofilm formation, meaning that more than one gene needs to be deleted to identify those genes whose functions are linked.
To approach the gene deletion challenge in C. albicans, a collaborative team led by James Collinsand George Church, two Core Faculty members at Harvard's Wyss Institute for Biologically Inspired Engineering, have developed a CRISPR-Cas9-based "gene drive" platform to create diploid strains of the pathogen in which both gene copies could be efficiently deleted. The technique may lead the way toward a better understanding of drug resistance and biofilm-forming mechanisms, and through future research, it could help pinpoint new drug targets and combination therapies. The study is published in Nature Microbiology.
The team took advantage of a recently discovered very rare "haploid" form of C. albicans which, like those of other fungi, only contains one set of chromosomes with one copy of each gene, but they can be mated to easily create the diploid form. "We used haploid C. albicans strains and replaced genes that we wanted to eliminate with a 'gene drive' that we previously developed and adjusted to the specific biology of C. albicans. After mating, these 'selfish genetic elements' proceed to replace the normal copy of the gene in the diploid fungi," said Church, Ph.D., who is a Professor of Genetics at Harvard Medical School and of Health Sciences and Technology at Harvard and MIT. "The approach worked so efficiently that it enabled us to even delete pairs of different genes simultaneously with higher throughput and to explore whether their functions are related."
The new gene drive approach is based on the CRISPR-Cas9 system, in which a DNA-cutting Cas9 enzyme is targeted to two regions that flank a gene in haploid C. albicans fungi by two so-called guide RNAs (gRNAs). After the targeted gene sequence has been cut out, an engineered gene drive cassette expressing all Cas9 and gRNA components is inserted in its place. When two haploid fungi are mated to form diploid offspring, the gene drive will also substitute the gene's counterpart in the other chromosome, effectively deleting the original version from the organism entirely.
By applying their gene deletion approach, the team was able to identify combinations of genes that act synergistically in defying certain drugs, or in triggering biofilm formation. "For example, deleting either the two efflux pump-encoding genes CDR1 and CDR2, or TPO3 and CDR2 together, rendered C. albicans highly sensitive to fluconazole and other antifungal drugs, suggesting that targeting two mechanisms at the same time could help overcome drug resistance," said Rebecca Shapiro, Ph.D., a Postdoctoral Fellow in Collins' team. Shapiro teamed up with Alejandro Chavez, Ph.D., as first co-authors on the publication. Chavez is a former Postdoctoral Fellow who worked with Church and Collins; he is now an Assistant Professor at New York's Columbia University. "In biofilm formation assays, we also found that loss of the ALS3 adhesion factor gene synergizes with the loss of several other adhesion factor genes, which makes it a highly interconnected hub of biofilm adhesion and an interesting candidate to further explore."
The study offers new inroads into understanding the difficult territory of C. albicans pathogenesis and drug resistance. "We can now get a much better handle on how genetic networks that underlie the virulence of C. albicans are organized, see how they respond to specific environmental and drug perturbations, and thereby uncover new vulnerabilities, that in the future may lead to new drug targets and combination therapies," said Collins, Ph.D., who also is the Termeer Professor of Medical Engineering & Science at Massachusetts Institute of Technology (MIT) and a Professor of Biological Engineering at MIT. "Moreover, our gene drive array platform can be a blueprint for similar approaches in other fungal pathogens, such as the newly emerging Candida auris, which is highly drug resistant and has already been marked as a threat by the Centers for Disease Control and Prevention."
"This symbiotic collaboration between faculty leaders of two of the Wyss Institute's Enabling Technology Platforms, Jim Collins and George Church, led to important new insights into the the biology of this infectious fungal pathogen and how it develops resistance, in addition to opening an entirely new path for design of more effective antifungal therapies," said Wyss Institute Founding Director Donald Ingber, M.D., Ph.D., who is also the Judah Folkman Professor of Vascular Biology at HMS and the Vascular Biology Program at Boston Children's Hospital, as well as Professor of Bioengineering at SEAS.